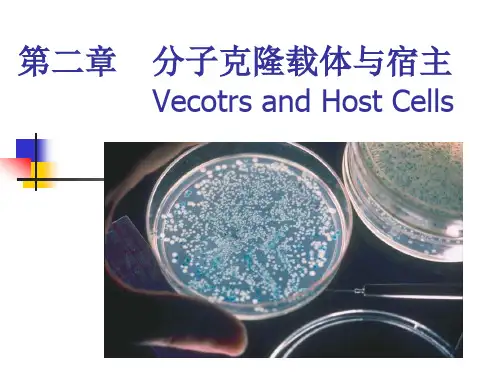

第二章 分子克隆载体与宿主
- 格式:ppt
- 大小:9.14 MB
- 文档页数:126

三四章分⼦克隆载体---答案_完_第三章分⼦克隆载体(Molecular cloning vectors)⼀、名词解析1.质粒:质粒是染⾊体外的遗传因⼦,能进⾏⾃我复制(但依赖于宿主编码的酶和蛋⽩质);⼤多数为超螺旋的双链共价闭合环状DNA分⼦(covalently closed circle , cccDNA),少数为线性;⼤⼩⼀般为1~200Kb,有的更⼤。
2.质粒拷贝数:质粒拷贝数(plasmid copy numbers)是指细胞中单⼀质粒的份数同染⾊体数之⽐值,常⽤质粒数/每染⾊体来表⽰。
不同的质粒在宿主细胞中的拷贝数不同。
3.质粒的不相容性:两个质粒在同⼀宿主中不能共存的现象称质粒的不相容性,它是指在第⼆个质粒导⼊后,在不涉及DNA 限制系统时出现的现象。
不相容的质粒⼀般都利⽤同⼀复制系统,从⽽导致不能共存于同⼀宿主中。
4.质粒的转移性:质粒具转移性。
它是指在⾃然条件下,很多质粒可以通过称为细菌接合的作⽤转移到新宿主内。
它需要移动基因 mob ,转移基因 tra ,顺式因⼦ bom 及其内部的转移缺⼝位点 nic。
5.穿梭质粒:既能在真核细胞中繁殖⼜能在原核细胞中繁殖的载体。
这类载体必须既有细菌的复制原点或质粒的复制原点,⼜含有真核⽣物的复制原点,还具备酶切位点和合适的筛选指标。
它⽤来转化细菌,⼜可以⽤于转化真核细胞。
6.α-互补:α-互补是指 lacZ 基因上缺失近操纵基因区段的突变体与带有完整的近操纵基因区段的β-半乳糖苷酶(β -galactosidase ,由 1024 个氨基酸组成)阴性的突变体之间实现互补。
α-互补是基于在两个不同的缺陷β-半乳糖苷酶之间可实现功能互补⽽建⽴的7.温和噬菌体:既能进⼊溶菌⽣命周期⼜能进⼊溶源⽣命周期的噬菌体。
8.溶源性细菌:具有⼀套完整的噬菌体基因组的细菌叫溶源性细菌。
9.整合:如果噬菌体的DNA是被包容在寄主细菌染⾊体DNA中,便叫做已整合的噬菌体DNA。





第二章分子克隆工具酶一、选择题1.有关基因工程的叙述正确的是()A.限制性内切酶只在获得目的基因时才用B.重组质粒的形成在细胞内完成C.质粒都可作运载体D.蛋白质的结构可为合成目的基因提供资料2.限制性内切酶EcoRⅠ在野生型的λ噬菌体DNA中有5个切点,Hind Ⅲ有7个切点。
调整这些酶切位点的数量,主要通过()。
A.体内突变B.完全酶切后连接C.部分酶切D.先用甲基化酶修饰后再酶切二、填空题1.如果用限制性内切核酸酶切割双链DNA产生5‟突出的黏性末端,则可以用__________进行3‟末端标记。
如果用限制性内切核酸酶切割DNA产生的是3‟突出的黏性末端,可以用__________________ 进行3‟末端标记。
2.可用T4 DNA聚合酶进行平末端的DNA标记,因为这种酶具有____________和_______的活性。
三、判断题1. pBR327是在pBR322的基础上去掉了1089bp的片段,留下了ampR和tetR的完整片段。
pBR327比pBR322有更高的拷贝,每个细胞中含有30-45个拷贝。
同时pBR327具有接合能力,能直接转入其他细胞()四、名词解释1. DNA聚合酶2. 限制性内切酶3. 甲基化酶4. T4-DNA连接酶5. 核酸酶6. Klenow酶7. T4 DNA聚合酶8. Taq DNA聚合酶9. 逆转录酶10. 同裂酶11. 核酶五、简答题1.限制性内切酶分为哪几大类,各有什么特点?2. DNA修饰酶主要有哪些,各有什么作用?3.简述Klenow聚合酶的用途。
4.比较E.coli DNA 连接酶和Taq DNA 连接酶的作用特点。
5.限制性内切酶I 的识别序列和切点是——GATCC G ↓,限制性内切酶II 的识别序列和切点是——GATC ↓。
在质粒上有酶I 的1个切点,在目的基因的两侧各有l 个酶II 的切点。
用上述两种酶分别切割质粒和含有目的基因的DNA 。

第三章 分子克隆载体第一节 分子克隆载体如果只有基因而没有负责运载它的载体,则基因就不可能发挥作用。
基因工程载体决定了外源基因的复制、扩增和表达。
载体的本质DNA。
载体(vector)就是指携带外源DNA片段进入宿主细胞进行扩增或表达的工具。
目前常用有载体有很多种,它们分别由从细菌质粒、噬菌体DNA、病毒DNA分离出的元件组装而成。
它们可分为克隆载体和表达载体,表达载体又分胞内表达和分泌表达载体。
从表达所用的受体细胞,又可分为原核细胞和真核细胞载体。
从功能上又可分为测序载体、克隆-转录载体和基因调控报告载体等多功能载体。
1.1 克隆载体1.1.1 克隆载体具备的条件①载体都能携带外源DNA片段(基因)进入受体细胞,或停留在细胞质中自我复制,或整合到染色体DNA上,随着染色体DNA的复制而同步复制。
②载体都具有合适的筛选遗传标记。
③载体都具有供外源基因插入的限制性核酸内切酶位点,即多克隆位点。
④载体都必须是安全的,不应含有对受体细胞有害的基因,并且不会任意转入除受体细胞以外的其他生物细胞,尤其是人的细胞。
⑤载体本身的分子量都比较小,可容纳较大的外源基因片段。
⑥载体在细胞内的拷贝数要高,方便外源基因在细胞内大量扩增。
⑦载体在细胞内稳定性要高,保证重组体稳定传代而不易丢失。
⑧载体的特征都是充分掌握的,包括它的全部核苷酸序列。
克隆载体在基因工程中占有十分重要的地位,目的基因能否有效转入受体细胞,并在其中维持和高效表达,在很大程度上取决于克隆载体。
基因工程是随着克隆载体系统的建立才发展起来的。
原核生物基因工程之所以起步早,发展快,成果大,就是因为最早建立了适用于原核生物的克隆载体系统,并且至今已建立了种类繁多的用于原核生物的大量克隆载体。
近十年来,植物基因工程所发展,同样是因为成功地构建了适用于植物的一系列的克隆载体。
因此,国内外把构建新的克隆载体始终作为基因工程基础研究的优先项目,构建的克隆载体可以申请专利保护。
